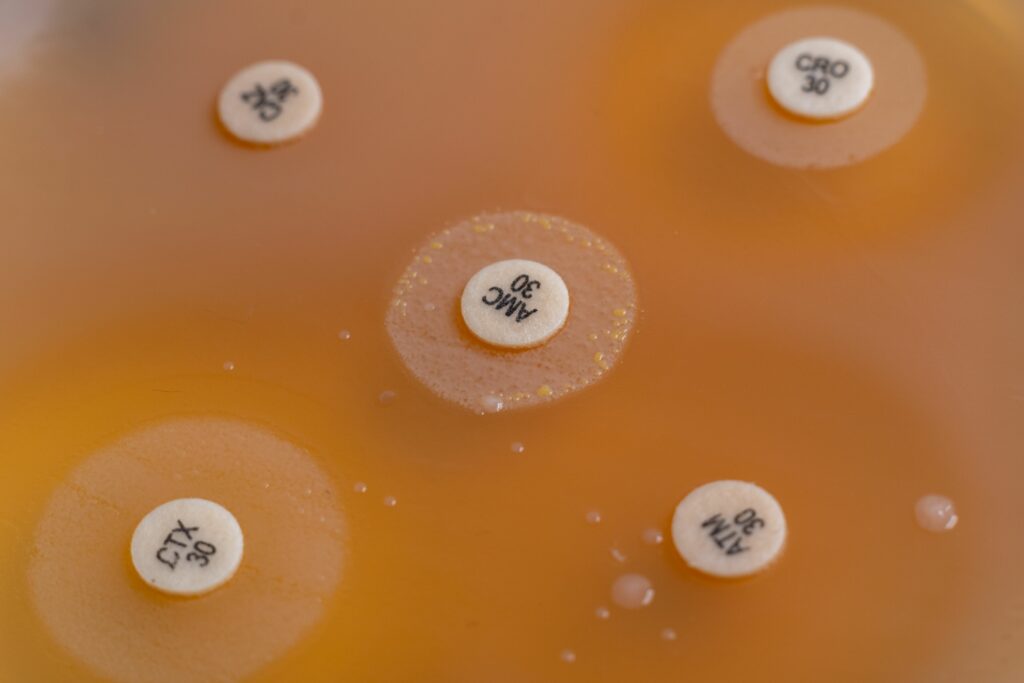
Microbiota, fibra y prebióticos: clave para tu salud digestiva

La salud intestinal está directamente relacionada con tu bienestar general. En este artículo exploramos cómo la microbiota, la fibra y los prebióticos influyen en tus digestiones, tu energía diaria y, sobre todo, en tus defensas. Como farmacia en el centro de Valencia, desde Farmacia Blanch te ofrecemos un consejo nutricional claro y práctico para mejorar tu salud desde dentro.
Qué es la microbiota intestinal y por qué importa
La microbiota intestinal es el conjunto de microorganismos que habitan en nuestro intestino. Lejos de ser un mero acompañante, cumple funciones esenciales: participa en la digestión, fortalece el sistema inmunitario y ayuda a sintetizar vitaminas clave. El equilibrio de esta microbiota está directamente vinculado con la salud digestiva, el estado de ánimo y la capacidad de defensa frente a infecciones. Cuando se altera —estrés, mala alimentación, antibióticos, falta de sueño— aparecen molestias digestivas, cansancio y mayor susceptibilidad a enfermedades.
Qué son los prebióticos y qué función cumplen
Los prebióticos son un tipo de fibra no digerible que sirve de alimento a las bacterias beneficiosas de la microbiota. A diferencia de los probióticos (bacterias vivas), los prebióticos favorecen su crecimiento y actividad. Son fundamentales para restaurar el equilibrio intestinal, mejorar la regularidad y potenciar la inmunidad. De hecho, si te preguntas qué prebióticos consumir, los más estudiados son la inulina, los fructooligosacáridos (FOS) y los galactooligosacáridos (GOS).
Alimentos con fibra y prebióticos que puedes incorporar fácilmente
Muchos alimentos cotidianos son grandes aliados para tu salud intestinal. Algunos ejemplos de alimentos ricos en fibra y prebióticos son:
- Ajo, cebolla y puerro.
- Plátano (especialmente el menos maduro).
- Alcachofa, espárragos y calabacín.
- Legumbres (lentejas, garbanzos, alubias).
- Avena integral.
- Semillas de chía y lino.
- Manzana con piel.
Incluirlos en tus comidas diarias favorece una microbiota más diversa y activa.
Cómo mejorar la microbiota para fortalecer defensas
La conexión entre microbiota y defensas es directa: más bacterias beneficiosas, mejor respuesta inmunitaria. Para reforzar tus defensas a través del intestino:
- Prioriza alimentos frescos y ricos en fibra.
- Incorpora prebióticos a diario.
- Valora añadir probióticos tras tratamientos antibióticos.
- Mantén buena hidratación.
- Intenta gestionar el estrés y dormir de forma regular.
Consulta aquí una guía científica sobre microbiota y sistema inmunitario
Recomendaciones prácticas
- Dosis diaria recomendada de fibra: entre 25 y 30 g al día.
- Prebióticos: incluir al menos una fuente en 1–2 comidas.
- Evita ultraprocesados: su exceso altera la microbiota y reduce la presencia de bacterias beneficiosas.
- Planifica tus comidas: facilita llegar a la cantidad de fibra y prebióticos recomendada.
- Consulta profesional: si tienes síntomas digestivos persistentes, pide una valoración personalizada en Farmacia Blanch.
Descubre más artículos de consejo nutricional en nuestro blog


